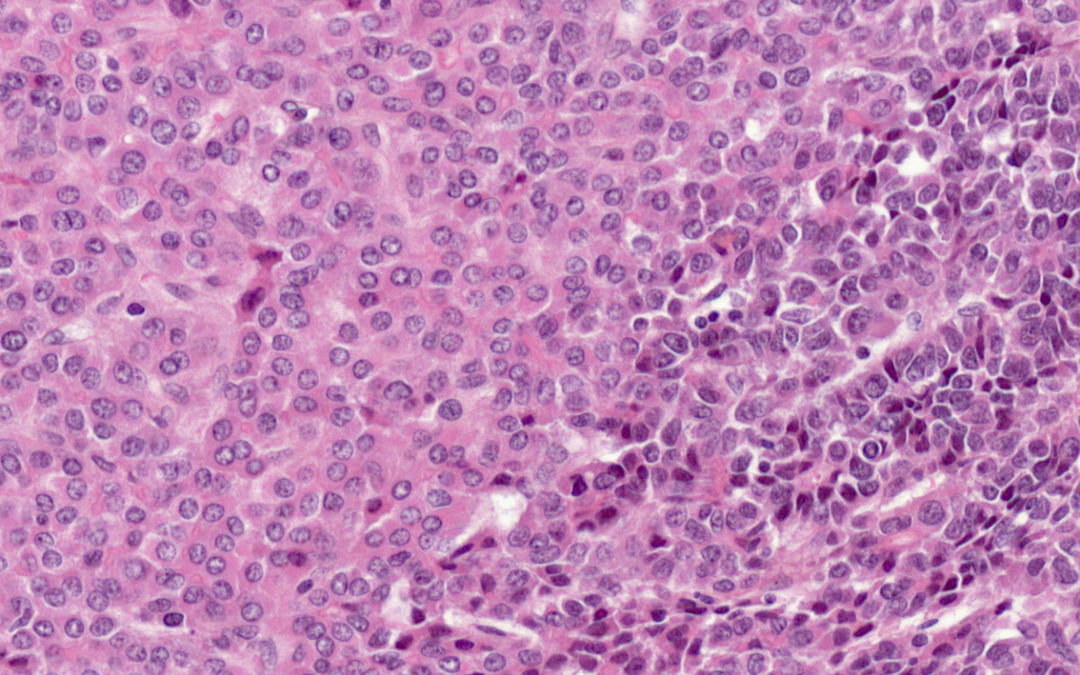
Cancers du foie de l&rsquo;enfant : plasticité tumorale et résistance à la chimiothérapie

26 mai 2021 | Accueil, International
Mareike Dalmann et Mouna Safir sont les titulaires de la bourse d’excellence « Eiffel », programme lancé en septembre dernier. Elles rejoindront Université Paris Cité pour cette rentrée académique. La campagne du programme Bourse d’excellence « Eiffel » a permis...

19 mai 2021 | Accueil, Recherche, Recherche Sociétés Humanités, Université Paris Cité
Découvrez comment la robe de chambre a façonné non seulement une nouvelle conception du confort intime mais aussi modifié les techniques de coupe des vêtements emblématiques de la mode du siècle des Lumières. Reportage au cœur des collections textiles du XVIIIe siècle...

17 mai 2021 | Accueil, Faculté des Sciences, Formation, Vie étudiante
Vous aimez les sciences et les jeux d’évasion ? Participez le 8, 10 ou 11 juin prochain à l’escape game « Masque-arade » créé et développé par des étudiants et étudiantes de la Faculté des Sciences, dans le cadre de l’UE « Escape game moléculaire ». Rejoignez...

11 mai 2021 | Accueil, Presse, Recherche, Recherche Santé
Combien de temps les symptômes de la Covid-19 peuvent-ils persister après une hospitalisation pour une infection par le SARS-CoV-2 ? Les scientifiques continuent à se poser de nombreuses questions sur ce virus émergeant et sur les conséquences à long terme de la...

10 mai 2021 | Accueil, Faculté de Santé, Faculté des Sciences, Formation, Non classé, Projet IDEX
Comment combiner analyse performante de données massives, enseignement à distance, sans aucune contrainte d’espace de stockage ou de connexion ? La réponse: PLASMA pour Plateforme d’e-Learning pour l’Analyse de données Scientifiques et MAssives. Ce projet...

6 mai 2021 | Accueil, Recherche, Université Paris Cité
L’analyse géochimique d’échantillons vieux de 4 milliards d’années a permis d’identifier les processus ayant menés à leurs formations. Une équipe dirigée par des scientifiques de l’IPGP démontre ainsi que la tectonique des plaques était déjà opérationnelle très tôt...

5 mai 2021 | Accueil, Presse, Recherche Santé
La perte de l’odorat, ou anosmie, est l’un des symptômes précoces les plus fréquents de la Covid-19. Les mécanismes impliqués dans cette anosmie étaient jusqu’ici non élucidés. Des chercheurs de l’Institut Pasteur, d’Université Paris Cité, du CNRS, de l’Inserm...

5 mai 2021 | Accueil, Presse, Recherche, Recherche Santé
Grâce à une importante analyse génomique des cancers du foie de l’enfant, l’équipe du Professeure Jessica Zucman-Rossi au Centre de Recherche des Cordeliers (Université Paris Cité, Inserm, Sorbonne Université), et ses collaborateurs du réseau Hepatobio,...

29 avril 2021 | Accueil, Recherche, Université Paris Cité
Audrey Michaud-Dubuy et Guillaume Carazzo, volcanologues à l’IPGP, reviennent sur l’éruption de la Soufrière de l’île de Saint-Vincent, dans les Petites Antilles, qui a provoqué l’évacuation d’une partie des habitants de l’île depuis le 8 avril. Au total, au...

28 avril 2021 | Accueil, Université Paris Cité
Université Paris Cité met à disposition une dalle de béton de 1100 m2 et un espace de 800 m2 en pleine-terre à un acteur de l’agriculture urbaine qui a pour mission de végétaliser le campus Necker, situé à côté de l’hôpital des enfants malades. © Illustration –...

28 avril 2021 | Accueil, Faculté des Sciences, Formation, Recherche, Recherche Sciences, Université Paris Cité
À l’initiative d’un groupe d’étudiants et étudiantes spécialistes des sciences des matériaux, Université Paris Cité a obtenu la reconnaissance d’une société savante internationale : la Materials Research Society (MRS). En constituant le premier « MRS University...

26 avril 2021 | Accueil, Presse, Recherche, Recherche Santé, Université Paris Cité
Suite aux cas de thromboses survenus après la vaccination contre la Covid-19, l’équipe du Pr David Smadja, professeur d’hématologie d’Université Paris Cité, membre du service d’hématologie de l’hôpital européen Georges-Pompidou AP-HP et directeur d’une équipe de...

23 avril 2021 | Accueil, Presse, Recherche, Recherche Sciences, Université Paris Cité
Le Conseil européen de la recherche a publié ce 22 avril, les résultats de son appel à projets « Advanced Grant », dédié aux chercheurs et chercheures en milieu de carrière. La France compte 22 lauréats et lauréates cette année dont cinq à Université Paris Cité :...
8 avril 2021 | Accueil, Appel à projet clos, Appel à projets IDEX , Formation
Suite au succès de l’appel à projets Innovations pédagogiques – Hybridation des formations et pédagogies innovantes, Université Paris Cité et ses partenaires de l’alliance Sorbonne Paris Cité (ASPC) poursuivent leur action en faveur de l’innovation...

7 avril 2021 | Accueil, Recherche, Recherche Santé
La Faculté de Santé d’Université Paris Cité rassemble la majorité des recherches sur les Maladies Ostéo-Articulaires, qu’elles soient fondamentales ou cliniques. L’Institut des Maladies OstéoArticulaires, créé en mars 2021, offre l’opportunité unique de réunir toutes...

1 avril 2021 | Accueil, Faculté de Santé, Faculté des Sciences, Faculté Sociétés et Humanités, Formation, International, Mobilité étudiante, Université Paris Cité
Le programme SMARTS-UP Graduate Schools d’Université Paris Cité vise à promouvoir l’internationalisation des formations de Master et faciliter l’accueil des meilleurs étudiants et étudiantes internationaux afin de constituer notamment un vivier d’excellence pour...